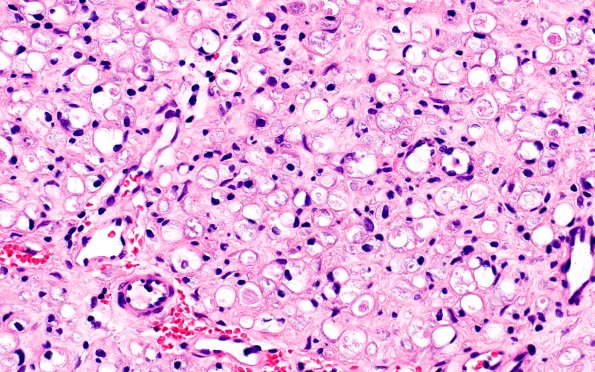
19A2 Trauma (Case 19) Proximal S1 root H&E Slide B1 40X

Table of Contents
Washington University Experience | PERIPHERAL NEUROPATHY | 19 TRAUMATIC INJURIES | 19A2 Trauma (Case 19) Proximal S1 root H&E Slide B1 40X
At higher magnification it appears that many of the cells are vacuolated Schwann cells or lipid-laden macrophages. (H&E)